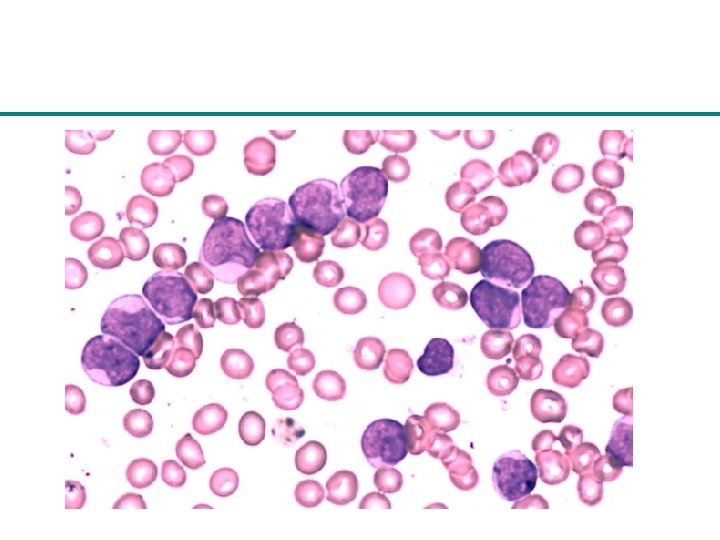

Stem Cells Cancer Norman Iscove M D Multiple

- Slides: 70
Stem Cells & Cancer Norman Iscove M. D.
Multiple kinds of blood cell
Bone marrow is a factory for blood cells
Multiple assembly lines in marrow
The neutrophil assembly line
The neutrophil assembly line
The neutrophil assembly line
The neutrophil assembly line
The neutrophil assembly line
The neutrophil assembly line
The neutrophil assembly line
The neutrophil assembly line
The neutrophil assembly line
The neutrophil assembly line
The neutrophil assembly line
The neutrophil assembly line
The neutrophil assembly line
Multiple assembly lines
Where do precursor cells come from?
Stem cells self-renew Stem cell Committed precursors Differentiating precursors
Stem cells self-renew Stem cell
Stem cells self-renew Stem cell
Stem cells self-renew Stem cell Committed precursor
Stem cells self-renew Stem cell Committed precursor Differentiating precursor
Stem cells self-renew Stem cell Committed precursors Differentiating precursors
Stem cells self-renew Stem cell
Stem cells self-renew Stem cell
Stem cells self-renew Stem cell Committed precursor
Stem cells self-renew Stem cell Committed precursor Differentiating precursor
Stem cells self-renew Stem cell Committed precursors Differentiating precursors
Stem cells self-renew Stem cell
Stem cells self-renew Stem cell
Stem cells self-renew Stem cell Committed precursor
Stem cells self-renew Stem cell Committed precursor Differentiating precursor
Stem cells are the key transplantable element in marrow Stem cells can be purified Imaging of stem cell transplantation 1 stem cell time Other precursors Stem cells 1 in 4, 000 1 in 20, 000 Cao et al. , PNAS 101: 221 -226, 2004
Normal blood cell formation • blood cells produced by maturation of precursor cells • precursor cells have finite proliferative capacity and lifespan • stem cells are multipotent • stem cells constantly replenish the precursor cells • stem cells make new stem cells - "self-renewal" • self-renewal is unique to stem cells and is essential for continued existence of blood cell production
Differing biology of precursor cells and stem cells proliferative
Differing biology of precursor cells and stem cells killed by anticancer drugs
Differing biology of precursor cells and stem cells quiescent
Differing biology of precursor cells and stem cells relatively resistant to anti-cancer drugs
Differing biology of precursor cells and stem cells • >95% of marrow cells can be depleted by treatment with certain anti-cancer drugs • stem cells may entirely resist short-term chemotherapy Despite massive reduction in marrow bulk by chemotherapeutic agents, marrow will rapidly regenerate from surviving stem cells
Stem cells in normal mammary glands 1 in 1500 mammary ductal cells can regenerate an entire gland 1 purified cell is sufficient Stingl et al, Nature 439: 993, 2006
Leukemia Normal
Leukemia initiating cells are rare and distinct leukemia cells human leukemia cells 1 in 50, 000 cells FACS time Stem cells 1% florid leukemia Remaining cells 99 % Dick et al, 1997
Breast tumour initiating cells are rare and distinct Human breast carcinoma cells breast tumour cells FACS time Stem cells 1% Breast carcinoma Remaining cells 99 % Clarke et al, 2003
Brain tumour initiating cells are rare and distinct Human brain tumour cells FACS time Stem cells 1% Brain tumour Remaining cells 99 % Dirks et al, 2004
Colon tumour initiating cells are rare and distinct Human colon carcinoma cells FACS time Stem cells 1% Colon carcinoma Remaining cells 99 % Dick et al, 2006
Cancer stem cells • cancers, like normal tissues, constitute differentiating systems • bulk cells produced by cancer systems have abnormal properties clinical disease • bulk cells have finite lifespans • cancer stem cells are rare and physically distinct from the bulk of tumour cells • cancer stem cells are essential to the continued existence of cancer systems • the biology of cancer stem cells differs from the rest of the cells in a tumour
Differing biology of precursor cells and stem cells relatively resistant to anti-cancer drugs killed by anticancer drugs
Stem cell concepts will change treatment strategies treatment remission relapse conventional bulk reduction eventual cure stem cell targetted combined antistem and bulk reduction early cure Tumour stem cell Jean Wang
Cancer stem cells - future work • new advances will be fuelled by the ability to detect cancer stem cells specifically • new drugs will be identified by their ability to destroy tumour forming cells rather than bulk tumour cells • stem cell-based treatment strategies will aim for cure
In leukemia, clinical illness requires interference with differentiation, mutational load may be complex In solid tumours, clinical change only requires local growth
Models of tumor heterogeneity STOCHASTIC MODEL NO TUMOR HIERARCHY MODEL NO TUMOR Jean Wang
Identification of cancer-initiating cells BRAIN CANCER HEAD & NECK CANCER BREAST CANCER COLON CANCER Injection into brain 2004 Subcutaneous injection 2007 Injection into mammary fat pad 2003 CD 133+ CD 44+CD 24 Injection under renal capsule or subcutaneous CD 133+ injection 2007 Intravenous injection 1997 AML CD 34+CD 38 Jean Wang
Development of effective anti-cancer therapies THERAPIES THAT KILL PROLIFERATING TUMOR CELLS BUT NOT C-ICs THERAPIES THAT KILL PROLIFERATING TUMOR CELLS AND C-ICs REMISSION RELAPSE Tumor shrinks Tumor regenerates Residual C-ICs Tumor degenerates CURE REMISSION CURE Jean Wang
The neutrophil assembly line
The neutrophil assembly line
The neutrophil assembly line
0 110 128 128 0 0 0 194 143 0 216 159 0 0 255 128 128 0 204 153 Test 2 Rholo. Ly 6 Ahic-kit+B 220 -CD 31 x 106
RKSL 9 Gy BM time CD 49 b- CD 49 b+ BMKL/FL/7/11 Onset of cell division
1 x 106 LTRC or STRC 100 cells 24 hr KL/FL/7/11 9 d
Stem Cells • persist throughout adult life • responsible for permanence of cellturnover systems • generate differentiating progeny • generate undifferentiated progeny that remain primitive
1. 0 0. 8 0. 6 0. 4 0. 2 0. 0 0 20 40 60 80
100 10 1 0 5 10 15 days 360
Leukemia
A new era in cancer stem cells • novel bioassays • growth factors / morphogens • surface markers Human acute myeloid leukemia is organized as a hierarchy that originates from a primitive hematopoietic cell. Bonnet D, Dick JE. Nat Med. 3: 730 -7, 1997 Prospective identification of tumorigenic breast cancer cells. Al-Hajj M, Wicha MS, Benito-Hernandez A, Morrison SJ, Clarke MF. Proc Natl Acad Sci USA. 100: 3547 -9, 2003 Identification of human brain tumour initiating cells. Singh SK, Hawkins C, Clarke ID, Squire JA, Bayani J, Hide T, Henkelman RM, Cusimano MD, Dirks PB. Nature. 432: 396 -401, 2004
Short term "CFC" assays BM cells 950 r